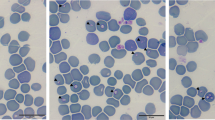

Abstract
To reveal the genetic diversity of Babesia microti and Theileria orientalis in Southwest China, we conducted a molecular survey of piroplasms in hard ticks in a China-Myanmar border county. Host infesting and questing ticks were collected from Tengchong County in 2013 and 2014. Piroplasm infection in ticks was detected by PCR, and then, phylogenetic analysis was conducted to study the genetic diversity of the pathogens identified in ticks. All in all, six piroplasm species comprising of B. microti; B. orientalis; a novel Babesia species designated Babesia sp. Tengchong, China; T. orientalis; T. luwenshuni; and an as yet undescribed piroplasmid species referred to as Piroplasmid sp. Tengchong, China, have been identified after screening goat- and cattle-attached ticks. In addition, B. bigemina has been identified by screening questing ticks. Phylogenetic analysis based on the 18S rRNA and partial β-tubulin gene revealed two novel potentially zoonotic genotypes designated B. microti Tengchong-Type A and B. The T. orientalis genotypes identified in the present study represent the seven known genotypes 1–5, 7, and N3 as revealed by phylogenetic analysis of 18S rRNA and MPSP genes. Importantly, an additional genotype designated N4 has also been identified in this study, which brings the number of recognized T. orientalis genotypes to a total of twelve. Thus, besides the two novel species, Babesia sp. Tengchong, China, closely related to Babesia species isolated from yak and Piroplasmid sp. Tengchong, China, our study demonstrates that additional novel B. microti and T. orientalis genotypes exist in Southwest China.
Similar content being viewed by others
Avoid common mistakes on your manuscript.
Introduction
As hematophagous ectoparasites, hard ticks (Acari: Ixodidae) can infest almost all vertebrates except fish and are able to transmit a wide range of pathogens, including bacteria, viruses, and parasites (Mansfield et al. 2017, Rehman et al. 2018). Therefore, ticks are considered one of the most important vectors of human and animal pathogens globally (Jongejan and Uilenberg 2004, Zhou et al. 2016). Babesia and Theileria, both belonging to Piroplasmida, are among the most widely distributed and economically important tick-borne, intraerythrocytic hemoparasites of wild and domestic mammals (Schnittger et al. 2012). Babesia is the second most commonly found hemoparasites of mammals after trypanosomes (Homer et al. 2000). Their infections of mammals are associated with mortalities, abortions, and decreased meat or milk production. Additionally, human babesiosis is also an increasing public health concern. Theileria parasites are important pathogens responsible for serious economic losses in the livestock industry worldwide. They can cause diseases with varying degrees of severity in various domestic and wild ruminants (Mans et al. 2015).
Several species of Babesia, including B. microti, B. venatorum, and B. divergens, can accidently infect humans and cause babesiosis. B. microti is the most common agent of human babesiosis (Moritz et al. 2016). In healthy people, infection with B. microti is usually asymptomatic. However, babesiosis can be fatal to immunocompromised persons. In recent years, the reported number of human babesiosis cases has increased substantially, and human babesiosis is considered to be a significant threat to public health worldwide (Chen et al. 2019). Originally three clades of B. microti (Clades 1 to 3) have been reported by Goethert and Telford (2003) based on phylogenetic analysis of the 18S rRNA or β-tubulin genes, and the same clade designation has been also used by Zhou et al. (2014). However, later it has been shown that Clade 2 (Goethert and Telford 2003, Zhou et al. 2014) exclusively comprises of Babesia sp. infecting carnivores (Baneth et al. 2015, 2019) that are now referred to as B. vulpes-group or Clade Ib (Jalovecka et al. 2019). Later phylogenetic studies showed that Clade 1 and 3 (Goethert and Telford 2003) represent a single large clade of Babesia sp. infecting rodents, humans, and macaque and that are currently referred to as B. microti-group or Clade Ia (Schnittger et al. 2012, Jalovecka et al. 2019, Baneth et al. 2015, 2019). In this later group, at least six different clades have been identified which are referred to as US-, Kobe-, Hobetsu- (or Otsu-), Munich-type, and Babesia sp. 1 and 2 that infect macaques (Baneth et al. 2015, Gao et al. 2017). Recently, human infections of B. microti have been increasingly reported in China, from the northern (e.g., Heilongjiang Province) to the southern area (including Zhejiang, Yunnan, Guangxi, and Taiwan Provinces) (Bloch et al. 2018, Chen et al. 2019). The infection routes of these human cases have not been well studied. However, most infections were possibly transmitted through tick bites, but blood transfusion cannot be excluded (Chen et al. 2019). As to now, little is known about the genetic diversity of B. microti in ticks from southwest China.
T. orientalis is a common agent of bovine and ovine theileriosis. This parasite is widely distributed in many Asia-Pacific countries (Bawm et al. 2014). Infection with T. orientalis often causes fever, anemia, and anorexia, thus reducing the productivity of domestic animals (Ota et al. 2009). The major piroplasm surface protein (MPSP) gene has been widely used for studying the genetic diversity of T. orientalis. To date, T. orientalis has been classified into 11 non-overlapping groups based on the MPSP gene, referred to as types 1–8 and N1-N3 (Sivakumar et al. 2014). T. orientalis infections in bovines have been reported in at least 19 provinces or municipalities of China, including Jilin, Liaoning, Tibet, Xinjiang, Inner Mongolia, Qinghai, Gansu, Guizhou, Sichuan, Shaanxi, Hebei, Jiangsu, Hubei, Hunan, Yunnan, Guangxi, Hainan, Fujian, and Chongqing (Qi et al. 2018, Qin et al. 2016, Wang et al. 2018). Only a limited number of studies have investigated the genetic diversity of T. orientalis in bovines in China. For example, a recent study showed that Types 1–5, 7, N1, and N2 existed in cattle from six provinces (Inner Mongolia, Qinhai, Shaanxi, Shandong, Hainan, Fujian) and Chongqing Municipality (Wang et al. 2018); another study detected Types 1, 2, 5 in dairy cattle from Xinjiang Province (Qi et al. 2018). Additional studies are required to assess the diversity and distribution of T. orientalis genotypes in ticks in China.
Tengchong is a China-Myanmar border county in Southwest China which is considered to be one of the epidemic foci of tick-borne diseases. In addition, several cases of human babesiosis have been reported in this area in recent years (Li et al. 2018, Zhou et al. 2013). Therefore, we conducted a molecular survey of piroplasms in hard ticks in Tengchong County, with a focus on the genetic diversity of B. microti and T. orientalis in this area.
Materials and methods
Tick collection and DNA extraction
The infesting and questing ticks used for the present study were collected from Tengchong County from May to June 2013 and September to October 2014. The procedures for tick collection were described previously (Li et al. 2018). In brief, infesting ticks were collected from the body surface of domestic animals, including cattle, goats, and dogs, and questing ticks were collected with a white drag cloth from the grazing locations. All tick specimens were preserved in 75% ethanol for subsequent processing. Before DNA extraction, each tick was washed three times with 75% ethanol for 1 min by vortexing and then rinsed three times with sterile phosphate-buffered saline (PBS). The DNA of the ticks was extracted using the DNeasy Blood & Tissue Kit (Qiagen, Hilden, Germany) following the manufacturer’s protocol.
Molecular detection of piroplasms in ticks
All DNA samples were first screened by nested PCR using a set of universal primers targeting the 18S rRNA gene fragment (Bab5 and Bab8 for the first round and Bab6 and Bab7 for the second) of most Babesia and Theileria species, including B. microti and T. orientalis (Kim et al. 2007). Samples with approximately 400-bp PCR products were considered positive. The positive PCR products were then purified and sequenced by Sangon Biotech (Shanghai, China). Each sequence was searched in GenBank using Nucleotide BLAST on the NCBI website (https://blast.ncbi.nlm.nih.gov/Blast.cgi).
All the samples with the highest identity to piroplasms were further amplified by nested PCR using two primer sets targeting the nearly full length of the 18S rRNA gene of piroplasms (Piro0F and Piro6R for the first round and Piro1F and Piro5.5R for the second) (Zhuang et al. 2018). Meanwhile, for samples with the highest identity to B. microti, nested PCR was further used to amplify the β-tubulin genes (BmTubu93F and BmTubu897R for the first round and BmTubu192F and BmTubu783R for the second round) (Zamoto-Niikura et al. 2012); for samples with the highest identity to T. orientalis, the MPSP genes were amplified using the primers MPSP-F and MPSP-R (Wang et al. 2018). All PCR products were purified, sequenced, and searched in NCBI GenBank as described above (additional data are given in electronic supplementary material (ESM) 1).
The primer sets used in the present study are shown in Table 1. The PCRs were conducted in a C1000 Touch™ Thermal Cycler (Bio-Rad Laboratories Incorporated, California, USA). Each 25 μl PCR mixture contained 12.5 μl of 2× PCR Master Mix (DBI Bioscience, Shanghai, China), 9.5 μl of water, 0.5 μl of each primer (10 mM), and 2 μl of DNA template. The PCR conditions were as follows: 95 °C for 3 min, followed by 35 cycles of 95 °C for 30 s, 57 °C for 30 s, and 72 °C for 40 s (for the primer set Piro0F–Piro6R, the extension time was 90 s), ending at 72 °C for 10 min.
Phylogenetic analysis of piroplasms in ticks
All sequences from the present study were first subjected to blast analysis on the NCBI website (https://blast.ncbi.nlm.nih.gov/Blast.cgi) after trimming the low-quality sequences at both ends. Then, representative nucleotide sequences of β-tubulin gene of B. microti and MPSP gene of T. orientalis were downloaded from GenBank for phylogenetic analysis. Meanwhile, 18S rRNA gene sequences of the detected organisms were also obtained from GenBank for phylogenetic analysis.
The sequences were aligned using ClustalW program in the Mega 5.1 software (Kumar et al. 1994). After eliminating all positions containing gaps and missing data, “Find best Model search” program was performed in the Mega 5.1 software. The model with the lowest Bayesian information criterion (BIC) score was considered to identify the most appropriate substitution pattern resulting in the selection of the Tamura-3 parameter model for phylogenetic analysis (Nei and Kumar 2000). Phylogenetic trees were then constructed based on the neighbor-joining (NJ) method, and 1000 bootstrap replicates using the Mega 5.1 software. Molecular classifications of the pathogens detected in ticks were determined by the results of phylogenetic analysis based on the 18S rRNA, β-tubulin, or MPSP genes.
Results
Molecular detection of piroplasms in ticks
A total of 930 infesting (502 from goats, 412 from cattle, and 16 from dogs) and 558 questing ticks of several species were collected, including Rhipicephalus microplus, R. haemaphysaloides, Ixodes ovatus, Haemaphysalis longicornis, and two unclassified Haemaphysalis species (Table 2). Ninety-one tick samples were positive for piroplasm according to the results of screening using the primer sets Bab5–Bab8. Seven species of piroplasm were identified, including four Babesia species (B. microti, B. bigemina, B. orientalis, and a novel Babesia sp. Tengchong, China), two Theileria species (T. orientalis and T. luwenshuni), and a previously unrecognized species referred to as Piroplasmid sp. Tengchong, China, of which it could not be determined whether it belongs to the Babesia or Theileria lineage (Table 2). T. orientalis was the most common hemoparasite in the tick samples (67 of the 91 positive samples), followed by B. microti (12 of the 91 positive samples).
As shown in Table 2, except for B. bigemina detected in questing ticks of the species R. microplus, all other piroplasms were detected in infesting ticks including the species R. microplus, I. ovatus, H. longicornis, and Haemophysalis sp. 1, but never in the tick species R. haemaphysaloides. All B. microti and Babesia sp. Tengchong, China, isolates were detected in goat-infesting I. ovatus; T. luwenshuni was detected in I. ovatus and R. microplus infesting goats. T. orientalis was found in ticks of R. microplus infesting goats and cattle and H. longicornis infesting goats, whereas B. orientalis was identified in R. microplus infesting cattle. The novel Piroplasmid sp. Tengchong, China, has been isolated from Haemaphysalis sp. 1 ticks infesting goats. All ticks positive for B. microti, Babesia sp. Tengchong, China, or T. luwenshuni were obtained from goats, while ticks positive for T. orientalis were obtained from goats or cattle. On the other hand, B. orientalis has been only identified in cattle.
Phylogenetic analysis of Babesia in ticks
Nearly full-length 18S rRNA genes and partial sequences of β-tubulin genes were obtained from all 12 B. microti-positive samples. All B. microti isolates from the present study clustered into the B. microti-group Clade Ia (Jalovecka et al. 2019) based on phylogenetic analysis of both the 18S rRNA (Fig. 1) and β-tubulin (Fig. 2) gene sequences (Baneth et al. 2015). Within the B. microti-group, the 18S rRNA and β-tubulin gene of B. microti isolates formed two corresponding separate novel clusters, and the respective isolates were designated B. microti Tengchong-type A and type B. Interestingly, these two B. microti isolates would be the first identified in goats.
Neighbor joining phylogenetic tree of the 18S rRNA gene of Babesia microti isolates. Sequences obtained in this study are indicated by an asterisk. The isolate designation, tick species, and host are given after the accession number. The bootstrap values determined by 1000 replicates are shown next to the branches. A B. rodhaini 18S rRNA gene sequence is included as the outgroup. The analysis involved 48 nucleotide sequences from which all positions containing gaps and missing data were eliminated resulting in a total of 1179 positions in the final dataset. The scale-bar shows the evolutionary distance in the units of the number of nucleotide substitutions per site
Neighbor joining phylogenetic tree of β-tubulin gene of Babesia microti isolates. Sequences obtained in this study are indicated by an asterisk. The isolate designation is given after the accession number. The bootstrap values determined by 1000 replicates are shown next to the branches. A β-tubulin gene sequence of B. rodhaini is included as the outgroup. The analysis involved 30 nucleotide sequences from which all positions containing gaps and missing data were eliminated resulting in a total of 522 positions in the final dataset. The scale-bar shows the evolutionary distance in the units of the number of nucleotide substitutions per site
In addition, two B. bigemina, one B. orientalis, and a novel Babesia sp. Tengchong, China, isolates were identified from ticks in this study as based on the phylogenetic analysis of nearly full-length sequences of the 18S rRNA gene (Fig. 3). Blast analysis showed that the sequence of Babesia sp. Tengchong, China, (MH208615) got the best hit with KX870104 (Babesia sp. isolated from yak, identity of 98.58%), and both formed a sister clade to the clade comprising B. venatorum and B. divergens (Fig. 3).
Neighbor joining phylogenetic tree of 18S rRNA gene of Babesia sensu stricto parasites (Schnittger et al. 2012). Sequences obtained in this study are indicated by an asterisk. The isolate designation, tick species, and host are given after the accession number. The bootstrap values determined by 1000 replicates are shown next to the branches. A Theileria equi 18S rRNA gene sequence is included as the outgroup. The analysis involved 20 nucleotide sequences from which all positions containing gaps and missing data were eliminated resulting in a total of 1414 positions in the final dataset. The scale-bar shows the evolutionary distance in the units of the number of nucleotide substitutions per site
Phylogenetic analysis of Theileria in ticks
Nearly full-length sequences of 18S rRNA gene were obtained from 12 of the 67 T. orientalis-positive samples, while partial MPSP sequences were recovered from 60 samples. Phylogenetic analysis based on the 18S rRNA gene and MPSP gene revealed that T. orientalis belonged to 7 known genotypes, namely, Types 1–5, 7, and N3 (Figs. 4 and 5). In addition, four MPSP sequences from this study and two sequences from other areas of China (MH180272 and MG664540) formed the new genotype T. orientalis Type N4.
Neighbor joining phylogenetic tree of the major piroplasm surface protein (MPSP) gene of Theileria orientalis. Sequences obtained in this study are indicated by an asterisk. The isolate designation, tick species, and host are given after the accession number. The bootstrap values determined by 1000 replicates are shown next to the branches. A T. annulata 18S rRNA gene sequence is included as the outgroup. The analysis involved 52 nucleotide sequences from which all positions containing gaps and missing data were eliminated resulting in a total of 551 positions in the final dataset. The scale-bar shows the evolutionary distance in the units of the number of nucleotide substitutions per site
Neighbor joining phylogenetic tree of Theileria spp. based on the 18S rRNA gene. Sequences obtained in this study are indicated by an asterisk. The isolate designation, tick species, and host are given after the accession number. The bootstrap values determined by 1000 replicates are shown next to the branches. A Babesia orientalis 18S rRNA gene sequence is included as the outgroup. The analysis involved 38 nucleotide sequences from which all positions containing gaps and missing data were eliminated resulting in a total of 1464 positions in the final dataset. The scale-bar shows the evolutionary distance in the units of the number of nucleotide substitutions per site
Nearly full-length sequences of the 18S rRNA gene were obtained from all 6 T. luwenshuni-positive samples and from two novel isolates designated Piroplasmid sp. Tengchong, China. Phylogenetic analysis showed that all sequences of T. luwenshuni clustered together (Fig. 5). Sequences of Piroplasmid sp. Tengchong, China, got the best hit with AB188086 (Piroplasmida sp. OtsuMNR, identity of 98.95%) by BLAST, and they formed a separate clade to T. bicornis.
Discussion
In the present study, we conducted a molecular survey of piroplasms in hard ticks in a China-Myanmar border county. Seven species of piroplasm were identified, including four Babesia species, two Theileria species, and one yet unrecognized piroplasmid species.
Babesia protozoa is the second most common parasite of mammals after trypanosomes, and more than 100 species of Babesia have been described so far (Antunes et al. 2017). B. microti is the most frequent pathogen of human babesiosis in China (Vannier and Krause 2015). I. persulcatus is reported to be the most important vector of B. microti in northeastern China (Zhou et al. 2014). However, potential vectors of this parasite in other regions of this country have not been thoroughly investigated (Li et al. 2016). Studies in Japan showed that I. ovatus ticks were also important vectors of B. microti (Saito-Ito et al. 2004, Zamoto-Niikura et al. 2018, Zamoto-Niikura et al. 2012). All isolates of B. microti in this study detected in I. ovatus ticks infested goats. However, it has been reported that goats are not suitable hosts for this parasite (Wu et al. 2017). Therefore, it may be assumed that the finding of B. microti in these ticks might be a result of previous ingestion of blood of infected small rodents, which are recognized animal reservoirs of B. microti (Vannier and Krause 2012). Notwithstanding, our results suggest that I. ovatus ticks are possible vectors of B. microti in southwest China.
Exclusively isolates segregating into the B. microti-group (Clade Ia, Jalovecka et al. 2019) have been found to infect humans. Of the six clusters within this group, B. microti strains infecting humans place exclusively into the US-, Kobe-, Hobetsu- (or Otsu-), and Munich-type clusters (Baneth et al. 2015, Gao et al. 2017, Schnittger et al. 2012). Importantly, neither the B. microti Tengchong-type A nor the Tengchong type B variant segregated in previously reported clusters (Schnittger et al. 2012; Baneth et al. 2015). Instead, all the B. microti isolates identified during this study form two additional separate groups within the B. microti-group (Clade Ia) as supported by 18S rRNA and β -tubulin gene sequence analysis (Figs. 1 and 2). Thus, at least two novel genotypes of B. microti exist in the study area. However, other reservoirs of these B. microti variants besides I. ovata and possibly goats are yet unknown and remain to be further elucidated.
T. orientalis is a common causative pathogen of bovine and ovine theileriosis (Wang et al. 2018). Correspondingly, T. orientalis parasites were detected in H. longicornis ticks or R. microplus ticks feeding on cattle or goats in our study. Up to date, 11 genotypes of T. orientalis (Types 1–8, and N1-N3) have been identified based on phylogenetic analysis of the MPSP sequences (Kamau et al. 2011, Sivakumar et al. 2014). Among known genotypes, at least eight have been reported in China, including Types 1–5, 7, N1, and N2 (Wang et al. 2018). In this study, seven of the known genotypes 1–5, 7, and N3 could be identified. In addition, a novel previously unknown genotype of T. orientalis designated type N4 has been identified (Fig. 4). Additional investigations will be necessary to elucidate the association of this novel genotype with disease.
There are several limitations to our study. First, except of two B. bigemina isolates, all of the identified hemoparasites originated from infesting ticks. Our study does therefore not allow reporting on the distribution and prevalence of piroplasmid species in the host or tick species. Second, the primer sets (Bab5–Bab8) used for piroplasm screening in the present study are not universal to all Babesia and Theileria species. For example, Bab5–Bab8 primers anneal to the Babesia Clade I (containing B. microti-group, B. vulpes-group, B. rodhaini, and B. felis-group; Schnittger et al. 2012, Jalovecka et al. 2019) and to most Theileria sp. However, inner primers Bab6 and Bab7 mismatch to Theileria species pertaining to Clade IV (including B. bicornis and T. equi, Schnittger et al. 2012). Thus this primer sets miss to amplify a considerable number of species. However, our study confirms that the species B. bigemina, B. orientalis, T. luwnshuni, the novel Babesia sp. Tengchong, China, and Piroplasmid sp. Tengchong, China, and the novel genetic variants of B. microti and T. orientalis are endemic in this area. Our study provides new insights into invertebrate and vertebrate host specificity, piroplasm species distribution and novel genotypes of tick-borne parasitic pathogens in southwest China.
References
Antunes S, Rosa C, Couto J, Ferrolho J, Domingos A (2017) Deciphering Babesia-vector interactions. Front Cell Infect Microbiol 7:429. https://doi.org/10.3389/fcimb.2017.00429
Baneth G, Florin-Christensen M, Cardoso L, Schnittger L (2015) Reclassification of Theileria annae as Babesia vulpes sp. nov. Parasit Vectors 8:207. https://doi.org/10.1186/s13071-015-0830-5
Baneth G, Cardoso L, Brilhante-Simoes P, Schnittger L (2019) Establishment of Babesia vulpes n. sp. (Apicomplexa: Babesiidae), a piroplasmid species pathogenic for domestic dogs. Parasit Vectors 12:129. https://doi.org/10.1186/s13071-019-3385-z
Bawm S, Shimizu K, Hirota J, Tosa Y, Htun LL, Maw NN, Thein M, Kato H, Sakurai T, Katakura K (2014) Molecular prevalence and genetic diversity of bovine Theileria orientalis in Myanmar. Parasitol Int 63:640–645. https://doi.org/10.1016/j.parint.2014.04.009
Bloch EM et al (2018) A pilot serosurvey of Babesia microti in Chinese blood donors. Vox Sang 113:345–349. https://doi.org/10.1111/vox.12648
Chen Z, Li H, Gao X, Bian A, Yan H, Kong D, Liu X (2019) Human Babesiosis in China: a systematic review. Parasitol Res 118:1103–1112. https://doi.org/10.1007/s00436-019-06250-9
Gao ZH, Huang TH, Jiang BG, Jia N, Liu ZX, Shao ZT, Jiang RR, Liu HB, Wei R, Li YQ, Yao HW, von Fricken M, Jiang JF, du CH, Cao WC (2017) Wide distribution and genetic diversity of Babesia microti in small mammals from Yunnan Province, southwestern China. PLoS Negl Trop Dis 11:e0005898. https://doi.org/10.1371/journal.pntd.0005898
Goethert HK, Telford SR (2003) What is Babesia microti? Parasitology 127:301–309
Homer MJ, Aguilar-Delfin I, Telford SR 3rd, Krause PJ, Persing DH (2000) Babesiosis. Clin Microbiol Rev 13:451–469. https://doi.org/10.1128/cmr.13.3.451-469.2000
Jalovecka M, Sojka D, Ascencio M, Schnittger L (2019) Babesia life cycle - when phylogeny meets biology. Trends Parasitol 35:356–368. https://doi.org/10.1016/j.pt.2019.01.007
Jongejan F, Uilenberg G (2004) The global importance of ticks. Parasitology 129(Suppl):S3–S14. https://doi.org/10.1017/S0031182004005967
Kamau J, de Vos AJ, Playford M, Salim B, Kinyanjui P, Sugimoto C (2011) Emergence of new types of Theileria orientalis in Australian cattle and possible cause of theileriosis outbreaks. Parasit Vectors 4:22. https://doi.org/10.1186/1756-3305-4-22
Kim JY, Cho SH, Joo HN, Tsuji M, Cho SR, Park IJ, Chung GT, Ju JW, Cheun HI, Lee HW, Lee YH, Kim TS (2007) First case of human babesiosis in Korea: detection and characterization of a novel type of Babesia sp. (KO1) similar to ovine babesia. J Clin Microbiol 45:2084–2087. https://doi.org/10.1128/JCM.01334-06
Kumar S, Tamura K, Nei M (1994) MEGA: molecular evolutionary genetics analysis software for microcomputers. Comput Appl Biosci 10:189–191. https://doi.org/10.1093/bioinformatics/10.2.189
Li LH, Zhu D, Zhang CC, Zhang Y, Zhou XN (2016) Experimental transmission of Babesia microti by Rhipicephalus haemaphysaloides. Parasit Vectors 9:231–236. https://doi.org/10.1186/s13071-016-1517-2
Li LH, Zhang Y, Wang JZ, Li XS, Yin SQ, Zhu D, Xue JB, Li SG (2018) High genetic diversity in hard ticks from a China-Myanmar border county. Parasit Vectors 11:469. https://doi.org/10.1186/s13071-018-3048-5
Mans BJ, Pienaar R, Latif AA (2015) A review of Theileria diagnostics and epidemiology. Int J Parasitol Parasites Wildl 4:104–118. https://doi.org/10.1016/j.ijppaw.2014.12.006
Mansfield KL, Jizhou L, Phipps LP, Johnson N (2017) Emerging tick-borne viruses in the twenty-first century. Front Cell Infect Microbiol 7:298. https://doi.org/10.3389/fcimb.2017.00298
Moritz ED, Winton CS, Tonnetti L, Townsend RL, Berardi VP, Hewins ME, Weeks KE, Dodd RY, Stramer SL (2016) Screening for Babesia microti in the U.S. blood supply. N Engl J Med 375:2236–2245. https://doi.org/10.1056/NEJMoa1600897
Nei M, Kumar S (2000) Molecular evolution and Phylogenetics. Oxford University Press, New York
Ota N, Mizuno D, Kuboki N, Igarashi I, Nakamura Y, Yamashina H, Hanzaike T, Fujii K, Onoe S, Hata H, Kondo S, Matsui S, Koga M, Matsumoto K, Inokuma H, Yokoyama N (2009) Epidemiological survey of Theileria orientalis infection in grazing cattle in the eastern part of Hokkaido, Japan. J Vet Med Sci 71:937–944. https://doi.org/10.1292/jvms.71.937
Qi M, Cui Y, Song X, Zhao A, Bo J, Zheng M, Ning C, Tao D (2018) Common occurrence of Theileria annulata and the first report of T. ovis in dairy cattle from southern Xinjiang, China. Ticks Tick Borne Dis 9:1446–1450. https://doi.org/10.1016/j.ttbdis.2018.06.017
Qin G, Li Y, Liu J, Liu Z, Yang J, Zhang L, Liu G, Guan G, Luo J, Yin H (2016) Molecular detection and characterization of Theileria infection in cattle and yaks from Tibet plateau region, China. Parasitol Res 115:2647–2652. https://doi.org/10.1007/s00436-016-5011-8
Rehman K, Bettani MAK, Veletzky L, Afridi S, Ramharter M (2018) Outbreak of Crimean-Congo haemorrhagic fever with atypical clinical presentation in the Karak District of Khyber Pakhtunkhwa, Pakistan. Infect Dis Poverty 7:116. https://doi.org/10.1186/s40249-018-0499-z
Saito-Ito A, Yano Y, Dantrakool A, Hashimoto T, Takada N (2004) Survey of rodents and ticks in human babesiosis emergence area in Japan: first detection of Babesia microti-like parasites in Ixodes ovatus. J Clin Microbiol 42:2268–2270. https://doi.org/10.1128/JCM.42.5.2268-2270.2004
Schnittger L, Rodriguez AE, Florin-Christensen M, Morrison DA (2012) Babesia: a world emerging. Infect Genet Evol 12:1788–1809. https://doi.org/10.1016/j.meegid.2012.07.004
Sivakumar T, Hayashida K, Sugimoto C, Yokoyama N (2014) Evolution and genetic diversity of Theileria. Infect Genet Evol 27:250–263. https://doi.org/10.1016/j.meegid.2014.07.013
Vannier E, Krause PJ (2012) Human babesiosis. N Engl J Med 366:2397–2407. https://doi.org/10.1056/NEJMra1202018
Vannier E, Krause PJ (2015) Babesiosis in China, an emerging threat. Lancet Infect Dis 15:137–139. https://doi.org/10.1016/S1473-3099(14)71062-X
Wang J, Yang J, Liu J, Wang X, Xu J, Liu A, Li Y, Liu Z, Ren Q, Luo J, Guan G, Yin H (2018) Molecular detection and genetic diversity of Theileria orientalis in cattle in China. Parasitol Res 117:3689–3694. https://doi.org/10.1007/s00436-018-6023-3
Wu J, Cao J, Zhou Y, Zhang H, Gong H, Zhou J (2017) Evaluation on infectivity of Babesia microti to domestic animals and ticks outside the Ixodes genus. Front Microbiol 8:1915. https://doi.org/10.3389/fmicb.2017.01915
Zamoto-Niikura A, Tsuji M, Qiang W, Nakao M, Hirata H, Ishihara C (2012) Detection of two zoonotic Babesia microti lineages, the Hobetsu and U.S. lineages, in two sympatric tick species, Ixodes ovatus and Ixodes persulcatus, respectively, in Japan. Appl Environ Microbiol 78:3424–3430. https://doi.org/10.1128/AEM.00142-12
Zamoto-Niikura A, Tsuji M, Qiang W, Morikawa S, Hanaki KI, Holman PJ, Ishihara C (2018) The Babesia divergens Asia lineage is maintained through enzootic cycles between Ixodes persulcatus and Sika deer in Hokkaido, Japan. Appl Environ Microbiol 84:e02491–e02417. https://doi.org/10.1128/AEM.02491-17
Zhou X, Li SG, Chen SB, Wang JZ, Xu B, Zhou HJ, Ge HX, Chen JH, Hu W (2013) Co-infections with Babesia microti and Plasmodium parasites along the China-Myanmar border. Infect Dis Poverty 2:24. https://doi.org/10.1186/2049-9957-2-24
Zhou X, Xia S, Huang JL, Tambo E, Zhuge HX, Zhou XN (2014) Human babesiosis, an emerging tick-borne disease in the People's Republic of China. Parasit Vectors 7:509–510. https://doi.org/10.1186/s13071-014-0509-3
Zhou Y, Zhang H, Cao J, Gong H, Zhou J (2016) Epidemiology of toxoplasmosis: role of the tick Haemaphysalis longicornis. Infect Dis Poverty 5:14. https://doi.org/10.1186/s40249-016-0106-0
Zhuang L, du J, Cui XM, Li H, Tang F, Zhang PH, Hu JG, Tong YG, Feng ZC, Liu W (2018) Identification of tick-borne pathogen diversity by metagenomic analysis in Haemaphysalis longicornis from Xinyang, China. Infect Dis Poverty 7:45–48. https://doi.org/10.1186/s40249-018-0417-4
Funding
This work was partially supported by the Special Fund for Basic Resources in Science and Technology (no. 2017FY101203), the National Key Research and Development Program of China (nos. 2016YFC1200500 and 2016YFC1202001), the fourth round of the Three-Year Public Health Action Plan (no. GWIV-29), Shandong Provincial Natural Science Foundation (no. ZR2019MH093), and National Natural Science Foundation of China (no. 81902095).
Author information
Authors and Affiliations
Contributions
LHL designed the investigation, performed the experiments and drafted the manuscript. JZW, DZ, XSL, SQY, and ZGL conducted the field investigation. YL performed the experiments and data analysis. YZ and XNZ conceived the study and revised the manuscript. All authors read and approved the final manuscript.
Corresponding author
Ethics declarations
Competing interests
The authors declare that they have no competing interests.
Ethics statement
No specific permits were required for this study. The study did not involve endangered or protected species. Therefore, the local ethics committee deemed approval unnecessary.
Additional information
Section Editor: Leonhard Schnittger
Publisher’s note
Springer Nature remains neutral with regard to jurisdictional claims in published maps and institutional affiliations.
Electronic supplementary material
ESM 1
(XLSX 32 kb)
Rights and permissions
About this article
Cite this article
Li, LH., Wang, JZ., Zhu, D. et al. Detection of novel piroplasmid species and Babesia microti and Theileria orientalis genotypes in hard ticks from Tengchong County, Southwest China. Parasitol Res 119, 1259–1269 (2020). https://doi.org/10.1007/s00436-020-06622-6
Received:
Accepted:
Published:
Issue Date:
DOI: https://doi.org/10.1007/s00436-020-06622-6